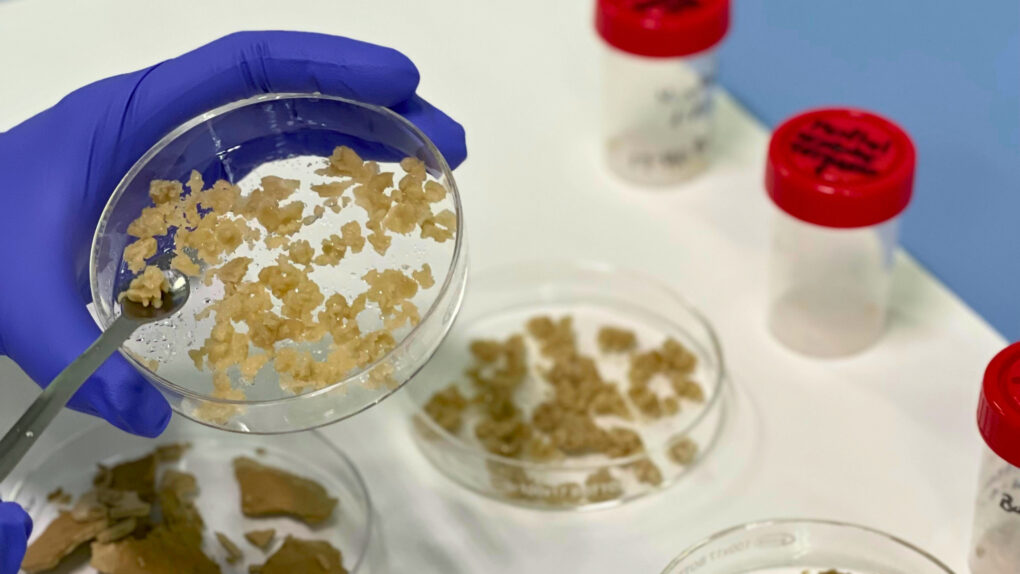

CTC desarrolla un fertilizante de liberación controlada sin impacto ambiental
El Centro Tecnológico CTC ha presentado un sistema innovador para la liberación controlada de fertilizantes sin impacto ambiental. Se trata de uno de los principales hitos del proyecto europeo AGRO4AGRI, centrado en el desarrollo de agroquímicos biodegradables y seguros, y cuya financiación procede del programa Horizonte Europa, con una inversión de 5,3 millones de euros.
El objetivo del proyecto es avanzar hacia una agricultura más sostenible, reduciendo el uso de insumos y mejorando la protección de cultivos. Para ello, se están desarrollando fertilizantes y pesticidas avanzados a partir de materiales innovadores como la nanotecnología o los materiales biobasados. Entre los productos en desarrollo se encuentran nematicidas específicos, destinados a favorecer el desarrollo de especies concretas. Si se cumplen las previsiones, el uso de pesticidas podría reducirse en más del 50%.
 El consorcio de AGRO4AGRI está formado por doce entidades de siete países, lideradas por el centro tecnológico AINIA (Valencia). El CTC, único representante cántabro, ha ejercido como anfitrión de las dos primeras jornadas de trabajo del proyecto, celebradas en Santander. En estos encuentros han participado una treintena de investigadores para evaluar el primer año de actividad.
El consorcio de AGRO4AGRI está formado por doce entidades de siete países, lideradas por el centro tecnológico AINIA (Valencia). El CTC, único representante cántabro, ha ejercido como anfitrión de las dos primeras jornadas de trabajo del proyecto, celebradas en Santander. En estos encuentros han participado una treintena de investigadores para evaluar el primer año de actividad.
En este marco, el CTC ha logrado avances significativos en el desarrollo de un sistema de encapsulado químico que permite una liberación controlada y precisa del fertilizante al contacto con el agua, ya sea de lluvia o riego. Este sistema se basa en precursores naturales, como el mentol o los ácidos grasos, que han demostrado no tener impacto ambiental e incluso favorecer el crecimiento de las plantas.
Gracias a la nanotecnología, los fertilizantes se alojan en el interior de nanopartículas que permiten una dosificación más lenta y constante. Mientras que los fertilizantes convencionales liberan sus nutrientes en un plazo de entre 4 y 10 días, el objetivo del proyecto es alcanzar los 30 días de efectividad. Esto permitiría reducir significativamente la pérdida de nutrientes, ya que actualmente se estima que dos tercios de los fertilizantes aplicados se desperdician por el ritmo de absorción de las plantas.
El grupo de trabajo liderado por Ángel Yedra en el CTC ha progresado también en la caracterización de los nanocarriers, o nanotransportadores, que actúan como vehículos de los fertilizantes. Se están empleando materiales como nanoarcilla y sílica porosa, con elevada superficie específica, lo que permite usar menos cantidad de principio activo con los mismos efectos. En los ensayos, se ha alcanzado ya una impregnación del 80%, un porcentaje que garantiza una liberación sostenida de nutrientes.
Los primeros ensayos en campo se realizarán en cultivos de maíz, tomate y sandía en Valencia, Salamanca, Bélgica e Italia. No obstante, el consorcio pretende extender el uso de estas soluciones a otros cultivos y localizaciones.
El proyecto, que comenzó en mayo de 2024 en Paterna y tiene una duración de 48 meses, se inscribe en el marco de iniciativas como el Pacto Verde Europeo, la Política Agrícola Común (PAC) o la estrategia De la Granja a la Mesa. También responde a los Objetivos de Desarrollo Sostenible (ODS) de Naciones Unidas, al abordar desafíos como la contaminación y degradación del suelo, la eficiencia de los agroquímicos o la transición hacia sistemas alimentarios más sostenibles.
Entre las organizaciones participantes, además del CTC y AINIA, figuran la Universidad del Sur de Dinamarca (SDU), la Universidad Técnica de Dinamarca (DTU), la Fundación Cajamar, el Centro de Investigación Hoogstraten (Bélgica), la empresa SIPCAM OXON (Italia), el Instituto de Estudios Avanzados de Viena (IHS), la empresa gallega Syspro, la compañía de fertilizantes Mirat, el grupo FI Group (Portugal y España) y la consultora Optimat (Reino Unido).
🔬🌱 Rompe el algoritmo y mueve esta información por tus redes o mensajería. Lucha contra el odio con ciencia y conocimiento.
🧪🌍 Podemos hablar de agricultura sostenible gracias a apoyos como el tuyo. Súmate y hazte socia o socio por 5 euros al mes en elfaradio.com/hazte-socio


